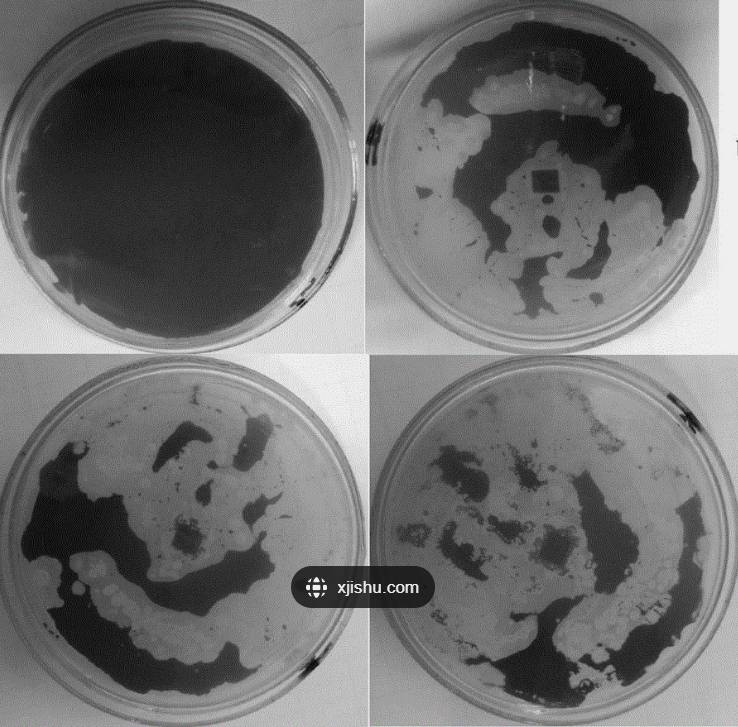

真菌标准菌株的质量控制和应用介绍
来源:武汉市灰藻生物科技有限公司 浏览量:355 发布时间:2024-11-21 22:49:08
真菌学鉴定
对真菌进行质量测试(表型和基因型检查),确保产品符合标准,确保菌株鉴定准确、培养物纯净且生化结果一致。
表型特征鉴定
对于丝状真菌,常见检查特征包括形态结构,如子实体和菌丝体,以及生命周期阶段的变化,如酵母阶段的存在与否。菌丝体通常由向各种基质分支生长的显微管状菌丝组成。这些纤维构成真菌的身体,通常被隔膜(septa)中断。隔膜的分布和变化因物种而异,可作为形态学鉴定的一部分。
除了菌丝结构分析,真菌鉴定还需要分析子实体。这些生殖结构是产生孢子的多细胞结构。子实体在真菌生命周期的有性阶段形成,不同物种之间的形态可能有所不同。真菌的繁殖阶段,包括无性繁殖阶段(anamorph)或有性繁殖阶段(teleomorph),也是真菌鉴定研究的一部分。
在分析如子囊菌门(Ascomycetes)和担子菌门(Basidiomycetes)等真菌菌株时,许多菌株在其生命周期的大部分时间里以酵母形式存在。观察它们的形态、繁殖方式及对各种碳水化合物的同化和发酵能力。通常,酵母是以单细胞生物存在的。
然而,某些物种也可以通过形成隔膜菌丝体或多形菌丝(pseudohyphae)来形成多细胞结构,后者是由出芽酵母保持连接形成的。这些复杂结构的形成或缺失往往指示了真菌的类型,可以作为物种鉴定过程的一部分。除了这些结构,酵母身份还通过观察到的繁殖方式来进行确认,无论是无性繁殖还是有性繁殖。在无性繁殖中,酵母通过分裂或出芽的方式形成子细胞。相反,单倍体酵母细胞能够通过有性繁殖。在这种形式的繁殖中,相对类型的单倍体酵母细胞首先进行“shmooing”(形成细长的细胞突起),然后融合形成一个二倍体细胞。最终形成的二倍体细胞再出芽,最终形成一个二倍体酵母细胞群。最后,酵母身份通过碳水化合物同化和发酵研究来确认。
基因型鉴定
检测核糖体亚单位及其间内部转录间隔区(ITS)区域基因型确认物种。具体来说,分析内部转录间隔区ITS1和ITS2、18S rRNA基因以及5.8S rRNA基因和28S rRNA基因的5'端(D1/D2高变区)。这些序列常用于分析酵母和真菌的系统发育和分类学,因为它们在真菌学物种中高度保守。
真菌学应用
酵母和真菌既可直接食用(大型丝状真菌,如蘑菇,灵芝等),也可通过发酵生产食品(各种酵母)。近年来,开始被用于生物医学和药理学、抗生素生产、生物燃料生产、生物控制和生物修复等。
生物医学和药理学
根据近年来医疗统计,真菌和酵母已成为低免疫人群真菌感染的主要原因,现有治疗方法需使用抗真菌药物。然而,这也推动了真菌自然选择,耐药菌株数量一直在稳步增加。为了开发和推进新的治疗策略,需要进行生物医学和药理学研究。病原性真菌和酵母菌株可以用作参考标准,以确定药物效力和所需强度。具有常见抗真菌耐药表型的临床菌株特别有助于药物发现,因为这些菌株可能是大多数医院的感染患病原因。
食品行业
酵母和真菌菌株常用于生产各种食品,包括蘑菇、面包、啤酒、葡萄酒、蓝纹奶酪和酱油。在面包、啤酒和葡萄酒的生产中,通常使用Saccharomyces等属的各种物种,发酵糖转化为乙醇和二氧化碳。这些产品的风味和质地受到酵母菌的影响。蓝纹奶酪通常由牛乳、羊乳或山羊乳奶酪制成,其中添加了Penicillium roqueforti或Penicillium glaucum等霉菌培养物。这些软质奶酪通常以其生产地点命名,如法国的Roquefort奶酪或意大利的Gorgonzola奶酪。最后,酱油由煮熟的大豆、烤谷物、盐水和Aspergillus oryzae或Aspergillus sojae霉菌发酵而成。

发酵食品
抗生素
抗生素是通过抑制细胞壁、蛋白质或DNA合成等多种机制,破坏或阻碍细菌或真菌微生物生长的化合物。目前许多抗生素来自Penicillium和Acremonium属真菌的代谢产物。这些属产生β-内酰胺类抗生素,这是一类以其特征环结构著称的抗生素。这类抗生素包括多种青霉素衍生物、头孢菌素和碳青霉烯类。青霉素衍生物如青霉素G、氨苄西林和阿莫西林通常来自Penicillium真菌。头孢菌素如头孢氨苄、头孢克洛和头孢地尼通常来自真菌Acremonium。真菌产抗生素是为了减少或消除可能有害,或竞争相同食物来源的菌种生长。在人类社会中,抗生素生产对于治疗传染病至关重要,并且经常用于农业上对植物病原微生物的生物控制。
生物燃料
目前,人类大部分能源来自石油、煤炭和天然气等不可再生能源,人们尝试用玉米和甘蔗等生产生物燃料作为可持续能源。当前生物燃料研究,集中在利用真菌分解纤维素成所需的碳氢化合物燃料化合物。目标是发现具有代谢途径的真菌菌株,这些代谢途径可以通过降解生物废物或杂草来生成生物燃料,从而在不减少食物供应的情况下,创造一种可持续的能源形式。
生物防控
生物防控是使用活体生物控制农业害虫(如昆虫或植物病原体),这是一种环境友好型的害虫控制手段,不会留下有害的化学残留物。虽然生物杀虫剂可以针对特定害虫种群,但也存在攻击有益物种的风险。不同的真菌已被用于通过竞争排斥、寄生或代谢产物来消灭害虫、杂草和疾病。例如,Beauveria bassiana、Paecilomyces fumosoroseus和Lecanicillium属的真菌被用于控制蚜虫、蓟马和粉虱等不同昆虫。其他真菌物种,包括Trichoderma属的物种,用于管理某些植物病原体,如榆树病或银叶病。

生物防控
生物修复
生物修复是指利用微生物代谢来清除环境中的污染物,在近几十年来已被用于降解诸如外来化合物、煤焦油和纸浆厂废料等危险化学品。
真菌降解废物的能力源于其分泌多种胞外酶。特别是真菌对木质素和纤维素的分解不仅在碳循环中是一个关键的代谢过程,还有助于纸基废物产品的分解,如纸浆或纸浆厂副产品。此外,木质素降解真菌,如黄孢原毛平革菌(Phanerochaete chrysosporium)、P. sordida 和 Trametes hirsuta,已被证明能够降解土壤中的五氯酚(PCP)和煤焦油。
除了降解五氯酚和煤焦油外,黄孢原毛平革菌已被证明能够降解多种有毒化合物,包括芳香烃、氯化有机物和氮芳香化合物。通过其强大代谢能力,能够转化或降解复杂的有机污染物,从而减轻环境污染。
生物修复特点
代谢范围广:真菌能够降解多种类型的有机污染物,包括石油烃、多环芳烃(PAHs)、多氯联苯(PCBs)和农药等。
高效降解:一些真菌,如黄孢原毛平革菌,具有高效的降解能力,能够在较短的时间内显著降低污染物浓度。
环境适应性强:能够在不同的环境条件下生长,包括土壤、水体和空气,这使得它们在多种环境中都能发挥作用。
低成本:相比物理和化学方法,生物修复成本较低,且对环境影响较小。
生态友好:不产生二次污染,有助于生态健康。
生物修复
生物修复应用实例
石油污染土壤修复:某些真菌能够降解石油烃,如白腐真菌(Phanerochaete chrysosporium)已被成功应用于石油污染土壤的修复。
多环芳烃(PAHs):真菌如 Trametes versicolor 能够有效降解多环芳烃,这些化合物在工业废料和燃烧过程中产生,对环境和人体健康造成威胁。
多氯联苯(PCBs):某些真菌如 Phanerochaete chrysosporium 能够降解多氯联苯,这些化合物在电气设备中广泛使用,但对环境和健康有严重危害。
农药降解:真菌如 Aspergillus niger 和 Trichoderma harzianum 能够降解多种农药,减少农田和水体中的农药残留。
参考资料
https://www.atcc.org/resources/culture-guides/mycology-culture-guide
敬请关注“灰藻视界”,共筑健康未来!
— 武汉市灰藻生物科技有限公司团队敬上
灰藻生物:我们期待着与客户共同成长,共同创造生命科学的未来!
更新日期:2024-11-21
#创作团队
编制人:小藻 | 审稿人:小灰